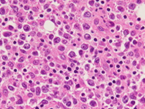
Ανοσοϊστοχημική χρώση για CD20, αποκαλύπτοντας την παρουσία μεγάλων, άτυπων, λεμφοειδών κυττάρων στην κυτταρική μεμβράνη (Ευγενική παραχώρηση Dr. V. Penopoulos)
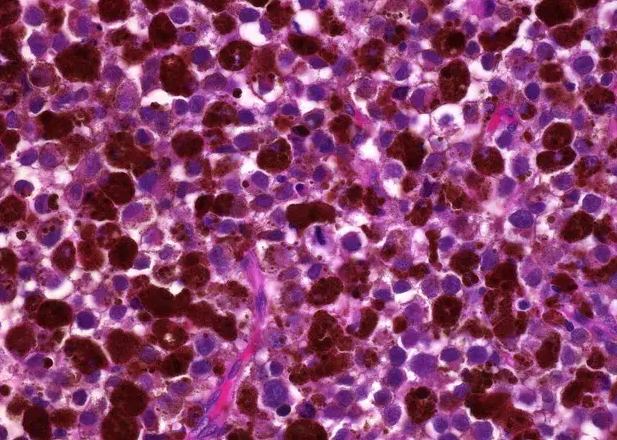
Ανοσοϊστοχημική εξέταση – Θετικότητα για δείκτη HMB45 (Ευγενική παραχώρηση Dr. V. Penopoulos)

Δέρμα & Μαλακά Μόρια
136 εικόνες

Ανοσοϊστοχημική χρώση, έντονα θετική για λεία μυοσίνη-ακτίνη (Ευγενική παραχώρηση Dr. V. Penopoulos)

Εκτεθέν λειομυοσάρκωμα αριστερής περιοχής ώμου (Ευγενική παραχώρηση Dr. V. Penopoulos)

Ανοσοϊστοχημική χρώση, έντονα θετική για βιμεντίνη (Ευγενική παραχώρηση Dr. V. Penopoulos)

Ανοσοϊστοχημική χρώση, έντονα θετική για λεία μυοσίνη-ακτίνη (Ευγενική παραχώρηση Dr. V. Penopoulos)

Ενδοπρωκτικό υπερηχογράφημα – Διήθηση πρωκτικού σωλήνα από το νεόπλασμα. Ευγενική παραχώρηση Dr. V. Penopoulos.

Μακροσκοπική εμφάνιση περινέου μετά από ριζική τοπική εκτομή. Ευγενική παραχώρηση Dr. V. Penopoulos.

Ενδοπρωκτικό υπερηχογράφημα – Πλήρης υποχώρηση νεοπλάσματος πρωκτού. Ευγενική παραχώρηση Dr. V. Penopoulos.

Εκτομή εξελκωμένης βλάβης Kaposi και μικροσκοπική άποψη (Ευγενική παραχώρηση Δρ. Β. Πενόπουλου)

Μη εξελκωμένες βλάβες σαρκώματος Kaposi στην πελματιαία επιφάνεια του δεξιού ποδιού (Ευγενική παραχώρηση Δρ. Β. Πενόπουλου)

Εκτομή εξελκωμένης βλάβης Kaposi και μικροσκοπική άποψη (Ευγενική παραχώρηση Δρ. Β. Πενόπουλου)

Εμφανής ο όζος λίγα εκατοστά από τον αριστερό ώμο (Ευγενική παραχώρηση Dr. V. Penopoulos)

Αμφοτερόπλευροι πνευμονικοί όζοι ενδεικτικοί μεταστάσεων μελανώματος (Ευγενική παραχώρηση Dr. V. Penopoulos)

Αριστερός μασχαλιαίος λεμφαδένας, Ki67 άνω 70%, θεραπευτική παρέμβαση (Ευγενική παραχώρηση Dr. V. Penopoulos)

Παθολογοανατομική εξέταση δερματικής βλάβης. Χρώση αιματοξυλίνης-εοσίνης που δείχνει φωλιές μονόμορφων καρκινικών κυττάρων με μεγάλη ατυπία, βαθυχρωματικούς πυρήνες και ενεργούς μιτωτικούς δείκτες χωρίς εμφανή μελανίνη (Ευγενική παραχώρηση Dr. V. Penopoulos)

Παθολογοανατομική εξέταση δερματικής βλάβης. Χρώση αιματοξυλίνης-εοσίνης που δείχνει φωλιές μονόμορφων καρκινικών κυττάρων με μεγάλη ατυπία, βαθυχρωματικούς πυρήνες και ενεργούς μιτωτικούς δείκτες χωρίς εμφανή μελανίνη (Ευγενική παραχώρηση Dr. V. Penopoulos)

Μακροσκοπική εικόνα εκτομαθέντος κυστικού νεοπλάσματος (Ευγενική παραχώρηση Dr. V. Penopoulos)

Η πλήρης αφαίρεση του λιπώματος είναι προφανής (Ευγενική παραχώρηση Dr. V. Penopoulos)

Η πλήρης αφαίρεση του λιπώματος είναι προφανής (Ευγενική παραχώρηση Dr. V. Penopoulos)

Η πλήρης αφαίρεση του λιπώματος είναι προφανής (Ευγενική παραχώρηση Dr. V. Penopoulos)

Λίπωμα. Παλαιά νέκρωση λίπους (FN) με ίνωση και δυστροφική ασβεστοποίηση. Τα νεκρωτικά λιποκύτταρα στερούνται πυρήνων (Ευγενική παραχώρηση Dr. V. Penopoulos)

Σχήμα 1 . Αξονική τομογραφία . Ογκώδης όγκος στον δεξιό γλουτό . ( Ευγενική παραχώρηση Δρ. Β. Πενόπουλος ) .

Ανοσοϊστοχημεία: θετικότητα για CD34 στα νεοπλασματικά κύτταρα (Ευγενική παραχώρηση Dr. V. Penopoulos).

Ανοσοϊστοχημεία: θετικότητα για CD99 στα νεοπλασματικά κύτταρα (Ευγενική παραχώρηση Dr. V. Penopoulos).

Σχήμα 3 . Είναι εμφανής η πλήρης εκτομή του όγκου . ( Ευγενική παραχώρηση Δρ. Β. Πενόπουλος ) .

Σχήμα 2 . Κομμένη επιφάνεια του όγκου που αφαιρέθηκε (Ευγενική παραχώρηση Δρ. Β. Πενόπουλος) .

Η ανοσοϊστοχημεία έδειξε θετική αντίδραση για CD34 (εικ. 3) και CD99 (εικ. 4) και αρνητικότητα για τον παράγοντα XIIIa. Ο ασθενής παραπέμφθηκε για χειρουργική εξαίρεση και θα παρακολουθείται στο τμήμα μετά την επέμβαση (Ευγενική παραχώρηση Dr. V. Penopoulos).

Σχήμα 2 . Εξαγόμενος όγκος - Επιφάνεια κοπής (ευγενική παραχώρηση Δρ. Β. Πενόπουλος) .

Σχήμα 1 . Η μαγνητική τομογραφία έδειξε μια καλά περιγεγραμμένη βλάβη με κυρίαρχη ένταση σήματος ισοδύναμου με το λίπος . ( Ευγενική παραχώρηση Δρ . Β . Πενόπουλος ) .

Η διάβρωση της ιερολαγόνιας άρθρωσης επέμεινε, αποδεικνύοντας τον καταστροφικό χαρακτήρα του νεοπλάσματος (Ευγενική παραχώρηση Dr. V. Penopoulos)

Πλήρης εξαφάνιση της αριστερής γλουτιαίας μάζας (Ευγενική παραχώρηση Dr. V. Penopoulos)

Η διάβρωση της ιερολαγόνιας άρθρωσης επέμεινε, αποδεικνύοντας τον καταστροφικό χαρακτήρα του νεοπλάσματος (Ευγενική παραχώρηση Dr. V. Penopoulos)
Ανοσοϊστοχημική χρώση για CD20, αποκαλύπτοντας την παρουσία μεγάλων, άτυπων, λεμφοειδών κυττάρων στην κυτταρική μεμβράνη (Ευγενική παραχώρηση Dr. V. Penopoulos)

Χρώση αιματοξυλίνης-ηωσίνης. Διάχυτη διήθηση από μεγάλα άτυπα λεμφοειδή κύτταρα με εμφανή πυρηνίσκο (Ευγενική παραχώρηση Dr. V. Penopoulos)

Σχήμα 2 . Μακροσκοπική άποψη του ινομυξοειδούς σαρκώματος που αφαιρέθηκε (ευγενική παραχώρηση Δρ. Β. Πενόπουλος) .

Σχήμα 3 . Χειρουργικό πεδίο μετά την εκτομή του σαρκώματος . (Ευγενική παραχώρηση Δρ. Β. Πενόπουλος) .

Αξονική τομογραφία κοιλίας. Φεβρουάριος 2017. Εμφανίζεται η υποτροπή του οπισθοπεριτοναϊκού αγγειοσαρκώματος (κόκκινα βέλη)

MRI οσφύος — Η βλάβη εμφανώς περιορίζεται στο δέρμα και τον υποδόριο ιστό (Ευγενική παραχώρηση Dr. V. Penopoulos)

Ερυθηματώδης, σκληρή, εξελκωμένη, αιμορραγούσα, πλατύβαση οσφυϊκή βλάβη (Ευγενική παραχώρηση Dr. V. Penopoulos)

MRI οσφύος — Η βλάβη εμφανώς περιορίζεται στο δέρμα και τον υποδόριο ιστό (Ευγενική παραχώρηση Dr. V. Penopoulos)

Χρώση αιματοξυλίνης-ηωσίνης. Παρουσία διάσπαρτων άτυπων μιτωτικών φιγούρων, νεκρωτικών νεοπλασματικών κυττάρων και τυπικής σμηγματώδους διαφοροποίησης με κενοτοπιώδες κυτταρόπλασμα και κυματοειδή πυρηνικά περιγράμματα (Ευγενική παραχώρηση Dr. V. Penopoulos)

Χρώση αιματοξυλίνης-ηωσίνης. Παρουσία διάσπαρτων άτυπων μιτωτικών φιγούρων, νεκρωτικών νεοπλασματικών κυττάρων και τυπικής σμηγματώδους διαφοροποίησης με κενοτοπιώδες κυτταρόπλασμα και κυματοειδή πυρηνικά περιγράμματα (Ευγενική παραχώρηση Dr. V. Penopoulos)

Χρώση αιματοξυλίνης-ηωσίνης. Παρουσία διάσπαρτων άτυπων μιτωτικών φιγούρων, νεκρωτικών νεοπλασματικών κυττάρων και τυπικής σμηγματώδους διαφοροποίησης με κενοτοπιώδες κυτταρόπλασμα και κυματοειδή πυρηνικά περιγράμματα (Ευγενική παραχώρηση Dr. V. Penopoulos)

Χρώση αιματοξυλίνης-ηωσίνης. Παρουσία διάσπαρτων άτυπων μιτωτικών φιγούρων, νεκρωτικών νεοπλασματικών κυττάρων και τυπικής σμηγματώδους διαφοροποίησης με κενοτοπιώδες κυτταρόπλασμα και κυματοειδή πυρηνικά περιγράμματα (Ευγενική παραχώρηση Dr. V. Penopoulos)

Χρώση αιματοξυλίνης-ηωσίνης. Παρουσία διάσπαρτων άτυπων μιτωτικών φιγούρων, νεκρωτικών νεοπλασματικών κυττάρων και τυπικής σμηγματώδους διαφοροποίησης με κενοτοπιώδες κυτταρόπλασμα και κυματοειδή πυρηνικά περιγράμματα (Ευγενική παραχώρηση Dr. V. Penopoulos)

Μωβ βέλη: λιπώματα. Καφέ βέλος: αδενοκαρκίνωμα σμηγματώδους αδένα (Ευγενική παραχώρηση Dr. V. Penopoulos)

Χρώση αιματοξυλίνης-ηωσίνης. Παρουσία διάσπαρτων άτυπων μιτωτικών φιγούρων, νεκρωτικών νεοπλασματικών κυττάρων και τυπικής σμηγματώδους διαφοροποίησης με κενοτοπιώδες κυτταρόπλασμα και κυματοειδή πυρηνικά περιγράμματα (Ευγενική παραχώρηση Dr. V. Penopoulos)

Χρώση αιματοξυλίνης-ηωσίνης. Παρουσία διάσπαρτων άτυπων μιτωτικών φιγούρων, νεκρωτικών νεοπλασματικών κυττάρων και τυπικής σμηγματώδους διαφοροποίησης με κενοτοπιώδες κυτταρόπλασμα και κυματοειδή πυρηνικά περιγράμματα (Ευγενική παραχώρηση Dr. V. Penopoulos)

Χρώση αιματοξυλίνης-ηωσίνης. Στιβάδες/πλάκες και οζίδια διηθητικών βασαλοειδών βλαστικών κυττάρων, με περιοχές πλακώδους διαφοροποίησης, νέκρωσης και εστιακά ουδετεροφιλικά μικροαποστήματα (Ευγενική παραχώρηση Dr. V. Penopoulos)

Μωβ βέλη: λιπώματα. Καφέ βέλος: αδενοκαρκίνωμα σμηγματώδους αδένα (Ευγενική παραχώρηση Dr. V. Penopoulos)

Χρώση αιματοξυλίνης-ηωσίνης. Εκτεταμένη σμηγματώδης διαφοροποίηση των νεοπλασματικών κυττάρων σε όλη την έκταση της βλάβης με ευδιάκριτα σμηγματώδη οζίδια και εστίες απόπτωσης και νέκρωσης εντός των νεοπλασματικών νησίδων. Τα νεοπλασματικά κύτταρα παρουσιάζουν έντονη μιτωτική δραστηριότητα (Ευγενική παραχώρηση Dr. V. Penopoulos)

Χρώση αιματοξυλίνης-ηωσίνης. Παρουσία διάσπαρτων άτυπων μιτωτικών φιγούρων, νεκρωτικών νεοπλασματικών κυττάρων και τυπικής σμηγματώδους διαφοροποίησης με κενοτοπιώδες κυτταρόπλασμα και κυματοειδή πυρηνικά περιγράμματα (Ευγενική παραχώρηση Dr. V. Penopoulos)

Χρώση αιματοξυλίνης-ηωσίνης. Παρουσία διάσπαρτων άτυπων μιτωτικών φιγούρων, νεκρωτικών νεοπλασματικών κυττάρων και τυπικής σμηγματώδους διαφοροποίησης με κενοτοπιώδες κυτταρόπλασμα και κυματοειδή πυρηνικά περιγράμματα (Ευγενική παραχώρηση Dr. V. Penopoulos)

Χρώση αιματοξυλίνης-ηωσίνης. Παρουσία διάσπαρτων άτυπων μιτωτικών φιγούρων, νεκρωτικών νεοπλασματικών κυττάρων και τυπικής σμηγματώδους διαφοροποίησης με κενοτοπιώδες κυτταρόπλασμα και κυματοειδή πυρηνικά περιγράμματα (Ευγενική παραχώρηση Dr. V. Penopoulos)

Μωβ βέλη: λιπώματα. Καφέ βέλος: αδενοκαρκίνωμα σμηγματώδους αδένα (Ευγενική παραχώρηση Dr. V. Penopoulos)

Μωβ βέλη: λιπώματα. Καφέ βέλος: αδενοκαρκίνωμα σμηγματώδους αδένα (Ευγενική παραχώρηση Dr. V. Penopoulos)

Ανοσοϊστοχημική εξέταση – Θετικότητα για δείκτη HMB45 (Ευγενική παραχώρηση Dr. V. Penopoulos)
Ανοσοϊστοχημική εξέταση – Θετικότητα για δείκτη HMB45 (Ευγενική παραχώρηση Dr. V. Penopoulos)

Χρώση αιματοξυλίνης-ηωσίνης. Παρουσία διάσπαρτων άτυπων μιτωτικών φιγούρων, νεκρωτικών νεοπλασματικών κυττάρων και τυπικής σμηγματώδους διαφοροποίησης με κενοτοπιώδες κυτταρόπλασμα και κυματοειδή πυρηνικά περιγράμματα (Ευγενική παραχώρηση Dr. V. Penopoulos)

Χρώση αιματοξυλίνης-ηωσίνης. Παρουσία διάσπαρτων άτυπων μιτωτικών φιγούρων, νεκρωτικών νεοπλασματικών κυττάρων και τυπικής σμηγματώδους διαφοροποίησης με κενοτοπιώδες κυτταρόπλασμα και κυματοειδή πυρηνικά περιγράμματα (Ευγενική παραχώρηση Dr. V. Penopoulos)

Χρώση αιματοξυλίνης-ηωσίνης. Παρουσία διάσπαρτων άτυπων μιτωτικών φιγούρων, νεκρωτικών νεοπλασματικών κυττάρων και τυπικής σμηγματώδους διαφοροποίησης με κενοτοπιώδες κυτταρόπλασμα και κυματοειδή πυρηνικά περιγράμματα (Ευγενική παραχώρηση Dr. V. Penopoulos)

Χρώση αιματοξυλίνης-ηωσίνης. Παρουσία διάσπαρτων άτυπων μιτωτικών φιγούρων, νεκρωτικών νεοπλασματικών κυττάρων και τυπικής σμηγματώδους διαφοροποίησης με κενοτοπιώδες κυτταρόπλασμα και κυματοειδή πυρηνικά περιγράμματα (Ευγενική παραχώρηση Dr. V. Penopoulos)

Ιστοπαθολογική εξέταση που αποκαλύπτει παρουσία ατρακτοειδών κυττάρων με εμφανείς πυρήνες και μελανινική χρωστική (Ευγενική παραχώρηση Dr. V. Penopoulos)

Χρώση αιματοξυλίνης-ηωσίνης. Παρουσία διάσπαρτων άτυπων μιτωτικών φιγούρων, νεκρωτικών νεοπλασματικών κυττάρων και τυπικής σμηγματώδους διαφοροποίησης με κενοτοπιώδες κυτταρόπλασμα και κυματοειδή πυρηνικά περιγράμματα (Ευγενική παραχώρηση Dr. V. Penopoulos)

MRI μηροβουβωνικής πτυχής με σκιαγραφικό, που αναδεικνύει μαλακοτισθενή μάζα εκφυόμενη από τη μεγάλη σαφηνή φλέβα (Ευγενική παραχώρηση Dr. V. Penopoulos)

Μακροσκοπική εικόνα του εξαιρεθέντος κυστικού όγκου (Ευγενική παραχώρηση Dr. V. Penopoulos)

Επιθηλιοειδή κύτταρα με μέτριο πλειομορφισμό, ηωσινόφιλο κυτταρόπλασμα, εμφανή κυστικά πυρήνια, σπάνια ραβδοειδή κύτταρα και υαλώδεις εγκλεισμούς στο κυτταρόπλασμα που εκτοπίζουν εκκεντρικά τους πυρήνες (Ευγενική παραχώρηση Dr. V. Penopoulos)

Επιθηλιοειδή και ραβδοειδή κύτταρα που παρουσιάζουν θετικότητα για βιμεντίνη και κυτοκερατίνη (Ευγενική παραχώρηση Dr. V. Penopoulos)

Ιστοπαθολογική εξέταση της επιδερμοειδούς κύστης (Ευγενική παραχώρηση Dr. V. Penopoulos)

Σχήμα 5 . Πυώδης κρυοδερματίτιδα. Αποστήματα , παροχετευτικά ιγμόρεια και ουλές . (Ευγενική παραχώρηση Δρ . Β . Πενόπουλος ) .

Σχήματα 1 , 2 , 3 . Hidradenitis suppurativa . ( Ευγενική παραχώρηση Δρ. Β. Πενόπουλος ) .

































































